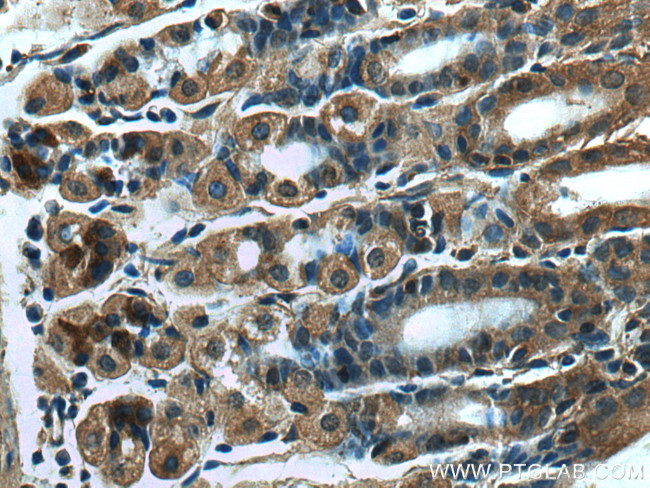
RSAD2 Antibody in Immunohistochemistry (Paraffin) (IHC (P))

Search
Proteintech
RSAD2 Polyclonal Antibody
{{$productOrderCtrl.translations['antibody.pdp.commerceCard.promotion.promotions']}}
{{$productOrderCtrl.translations['antibody.pdp.commerceCard.promotion.viewpromo']}}
{{$productOrderCtrl.translations['antibody.pdp.commerceCard.promotion.promocode']}}: {{promo.promoCode}} {{promo.promoTitle}} {{promo.promoDescription}}. {{$productOrderCtrl.translations['antibody.pdp.commerceCard.promotion.learnmore']}}
产品信息
28089-1-AP
种属反应
宿主/亚型
分类
类型
抗原
偶联物
形式
浓度
规格
纯化类型
保存液
内含物
保存条件
运输条件
产品详细信息
Aliquoting is unnecessary for -20°C storage.
靶标信息
Viperin is a 43kDa protein which is one of several hundred interferon inducible viral proteins. Elevated expression of viperin is induced by LPS and poly I:C through TLR dependent signaling pathways. Sendai virus mediated viperin expression is induced independently of TLR signaling pathways through RLRs - RIG-I and MAVs (Severa, 2006). Viperin has been shown to play an important role in interferon mediated anti-viral activity in a Hepatitis C virus model system (Helbig, 2011). Viperin is induced in lymphoid cells and dendritic cells (DCs) and highly induced in neutrophils and macrophages during acute LCMV infection in mice (Hinson, ). Viperin functions as a mediator of viral resistance and as a marker for interferon responsiveness making its detection and mechanism of action through specific antibody probes valuable for further studies.
仅用于科研。不用于诊断过程。未经明确授权不得转售。
生物信息学
蛋白别名: CIG5; Cytomegalovirus-induced gene 5 protein; Radical S-adenosyl methionine domain-containing protein 2; rsad2; S-adenosylmethionine-dependent nucleotide dehydratase RSAD2; SAND; unnamed protein product; VHSV-induced-like protein; Viperin; viral hemorrhagic septicemia virus (VHSV)-induced gene 1; Virus inhibitory protein, endoplasmic reticulum-associated, interferon-inducible
基因别名: 2510004L01Rik; cig33; CIG5; RSAD2; SAND; Vig1
UniProt ID: (Human) Q8WXG1, (Mouse) Q8CBB9
Entrez Gene ID: (Human) 91543, (Mouse) 58185